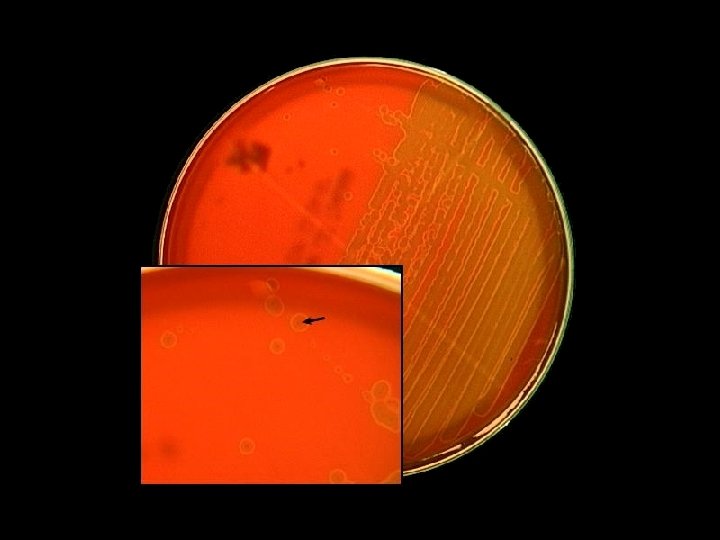
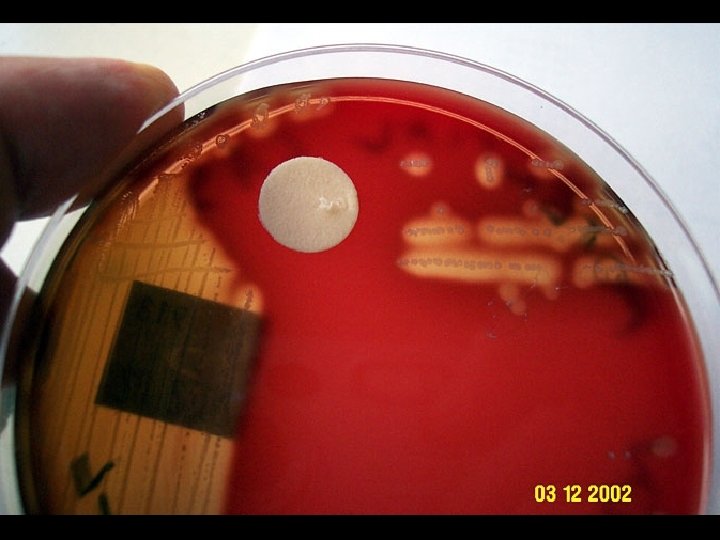

Streptococchi G Antonelli M Clementi G Pozzi G

- Slides: 50
--Streptococchi--
G. Antonelli, M. Clementi, G. Pozzi, G. M. Rossolini Principi di Microbiologia medica, II ed. Copyright 2011 C. E. A. Casa Editrice Ambrosiana
Habitat • Natura ubiquitaria • Isolati a livello di flora digestiva, respiratoria, vaginale, cutanea
R. A. Harvey, P. C. Champe, B. D. Fisher. Le basi della Microbiologia. Ed. Zanichelli
G. Antonelli, M. Clementi, G. Pozzi, G. M. Rossolini Principi di Microbiologia medica, II ed. Copyright 2011 C. E. A. Casa Editrice Ambrosiana
Streptococcus pyogenes • Streptococcus pyogenes was identified as early as 1884 from patients with skin infections. • It is identifiable as a spherical cell 0. 6 - 1. 0 m in diameter, occurring as pairs or as short chains in clinical specimens.
Fattori di virulenza di S. pyogenes: tossine citolitiche ed esoenzimi SPE: Streptococcal pyrogenic (A, B*, C, F) /erithrogenic (A, C) esotoxin Streptolisina O è un potente immunogeno: il titolo anti streptolisina O è un test molto importante per la diagnosi delle sequele non suppurative dell’infezione da S. pyogenes Spreading factor R. A. Harvey, P. C. Champe, B. D. Fisher. Le basi della Microbiologia. Ed. Zanichelli
Fattori di virulenza legati alla cellula • Capsula • Slime • • Proteina M Proteina F (adesina) Carboidrato C (? ) Proteina T (? ) S. pyogenes, S. pneumoniae Str. viridanti, enterococchi S. pyogenes Str. beta-emolitici S. pyogenes
Proprietà e struttura della proteina M di Streptococcus pyogenes • Variabilità antigenica (100 sierotipi) • Antifagocitaria (maschera il sito di legame del C 3 b) • Omologia di sequenze aminoacidiche con proteine fibrillari umane (miosina cheratina, tropomiosina) • Fattore di aggregazione batterico • Legame del frammento Fc delle Ig. G
S. pyogenes is responsible for a number of different diseases including: 1. Streptococcal pharyngitis (Streptococcal sore throat).
Pouvoir pathogène • Maladies post-streptococciques (1 -4 semaines) • Processus auto-immun (parenté antigéniques entre régions de la protéine M et les macromolécules tissulaires (laminine, myosine, collagène) • Pouvoir néphrotoxique ou rhumatogène de certains types de protéine M • Responsable de – rhumatisme articulaire aigu (RAA) : syndrome général avec syndrome articulaire. Formes cliniques : cardiaque (rétrécissement mitral), cutanées (nodosités souscutanées, érythème marginée), chorée de Sydenham (danse de St-Guy) – glomérulonéphrite aiguë: réaction immunitaire avec complexes circulants se déposant dans les capillaires du glomérule
S. pyogenes is responsible for a number of different diseases including: 2. Scarlet fever.
Pouvoir pathogène Infections toxiques • Scarlatine : angine + éruption cutanée • Conversion lysogénique par un bactériophage spécifique
S. pyogenes is responsible for a number of different diseases including: 3. Skin infections such as: • streptococcal pyoderma, a localised purulent skin infection; • erysipelas, spreading infection of the skin; • cellulitis, spreading infection of the skin and underlying tissue.
Invasive group A streptococcal infections appear to have increased in incidence in many parts of the world over the past 20 years
S. pyogenes is responsible for a number of different diseases including: 4. Necrotising fasciitis or 'Streptococcal gangrene', the 'flesh -eating disease'.
Activité des antibiotiques • Pénicillines G et V : toujours actives • Macrolides (si allergie pénicillines) : 20 -30 % de résistance • Clindamycine : effet post-antibiotique et action sur la synthèse des toxines et protéine M • Aminosides : inactifs seuls, actifs en association avec pénicilline
Streptococcus agalactiae Streptocoque du groupe B • • Réservoir principal: tube digestif Colonisation des voies génitales Portage vaginale entre 5%-40% Responsable de pathologie materno-fœtale – – – • Rupture prématurée des membranes Avortement Prématurité Infection précoce: septicémie < J 5 (80% des infections après 24 h) Infection tardive : méningite (> J 10 -3 mois) Traitement antibiotique préventif ou curatif : Mère: b-lactamines, macrolide Enfant: b-lactamine + aminoside
G. Antonelli, M. Clementi, G. Pozzi, G. M. Rossolini Principi di Microbiologia medica, II ed. Copyright 2011 C. E. A. Casa Editrice Ambrosiana
The “King of Pneumonia” Streptococcus pneumoniae is the classic cause of ‘lobar’ pneumonia, though its incidence has been challanged in recent years by that of the so-called atypical causes of pneumonia.
Bacteriology of Hospitalized CAP Woodhead MA, 1998
R. A. Harvey, P. C. Champe, B. D. Fisher. Le basi della Microbiologia. Ed. Zanichelli
Fattori di virulenza di S. pneumoniae: • capsula • tossine citolitiche (pneumolisina) Manifestazioni cliniche Infezioni delle alte via respiratorie -otiti, sinusiti Infezioni invasive -Polmoniti (la più frequente tra le polmoniti comunitarie) -Meningite (un terzo delle meningiti comunitarie nell’adulto) -Sepsi R. A. Harvey, P. C. Champe, B. D. Fisher. Le basi della Microbiologia. Ed. Zanichelli
Streptococcus pneumoniae is frequently isolated from sputum, but this finding is puzzling since it is also commonly found in the normal throat flora
R. A. Harvey, P. C. Champe, B. D. Fisher. Le basi della Microbiologia. Ed. Zanichelli
R. A. Harvey, P. C. Champe, B. D. Fisher. Le basi della Microbiologia. Ed. Zanichelli
R. A. Harvey, P. C. Champe, B. D. Fisher. Le basi della Microbiologia. Ed. Zanichelli
Prevalence of PNRP isolates (%) Prevalence of penicillin resistance S. pneumoniae Year Slide no Alexander Project data 1992– 1999 39
Mosaic PBPs • S. pneumoniae can absorb free DNA from the environment (transformation), thus developping resistance to betalactams by means of altered penicillin binding protein (PBP) Mosaic genes Altered PBP Transformation of S. pneumoniae Low affinity for beta-lactams
Mean proportions of erythromycin nonsusceptible and penicillin non-susceptible S. pneumoniae in Europe EARSS Annual Report 2004
R. A. Harvey, P. C. Champe, B. D. Fisher. Le basi della Microbiologia. Ed. Zanichelli
Enterococcus (faecalis, faecium, ecc): • carboidrato di gruppo D • α, β o non-emolitici Caratteristiche del genere • colonizzano l’intestino • scarsamente sensibili agli antibiotici e ai disinfettanti • patogeni opportunisti Identificazione: • resistenza alla bile • crescita in presenza di Na. Cl al 6, 5% • idrolisi dell’esculina
Agenti antimicrobici utilizzati nel trattamento delle infezioni causate da enterococchi β R. A. Harvey, P. C. Champe, B. D. Fisher. Le basi della Microbiologia. Ed. Zanichelli
Some Risk Factors for Nosocomial Acquisition of VRE Advanced patient age Prolonged hospitalization Severity of underlying illness Exposure to electronic thermometers Proximity to a known VRE case Enteral feedings
Areas of Normal Skin Colonized with Vancomycin-Resistant Enterococci Above waist 38% Hand or arm 29% Inguinal area 86% Bonten MJM et al. Lancet 1996; 348: 1615